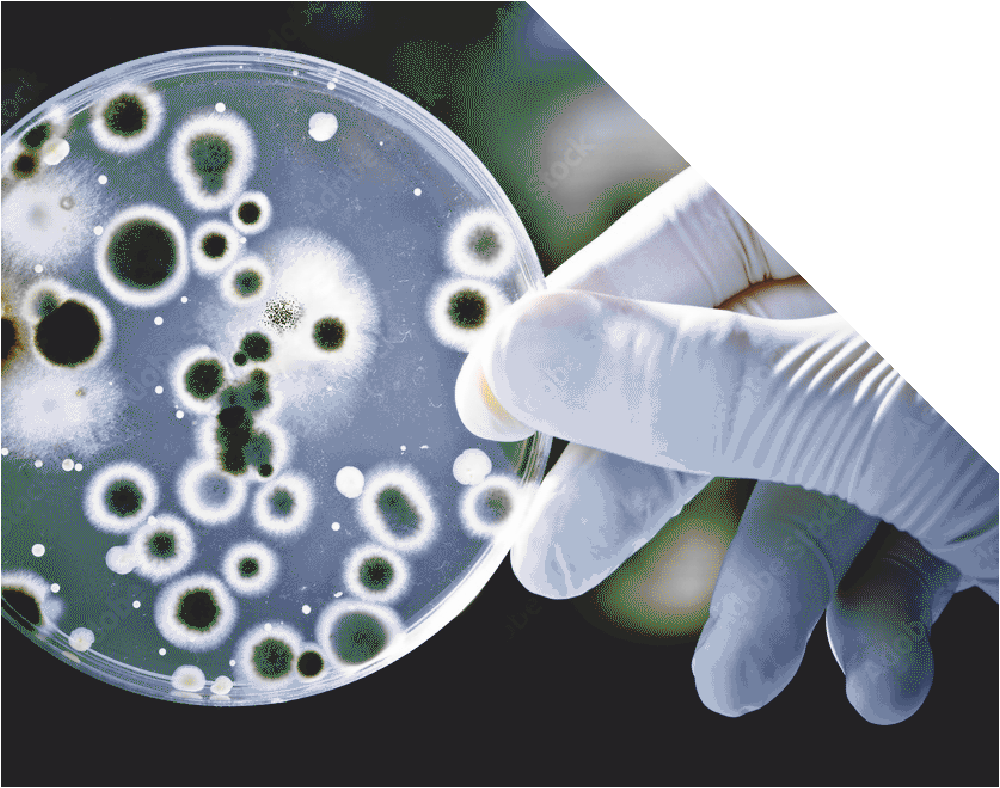

BIOLOGISCHES MESS & ANALYSELABOR
- Allergene und Allergie
Latexallergene, Milbenallergene /
Katzenallergene, Schimmelpilzallergene - Schimmelpilzanalytik
für kundenspezifische Fragestellungen - Seminare / Schulungen
- Bedarfsgegenstände / Qualitätskontrolle
z.B. Latexproteine, Bioburden
- Innenraum und Arbeitsplatz
Schimmelpilze - Antigene/Allergene in Luft mittels
AS 100/MBASS 30
Herzlich Willkommen
www.bma-labor.de

Durch die DAkkS nach DIN EN ISO/IEC 17025 akkreditiertes Prüflaboratorium.

BMA Labor

Das Labor
Die BMA-Labor GbR wurde im Juli 1999 als unabhängiges Auftragslabor gegründet…

Mitarbeiter
Unsere Mitarbeiter

Leistungen
Maßgeschneiderte Lösungen für unsere Kunden.
